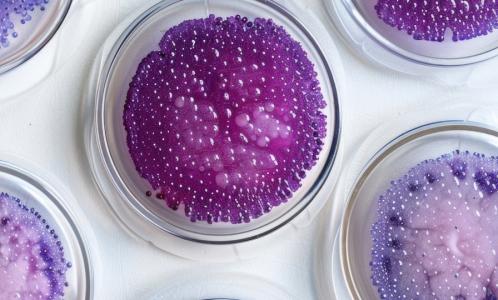
C'est la découverte d'un régulateur génétique qui améliore la santé des plantes (Visuel Adobe Stock 785712765)

LAVANDE : Ce gène régulateur protecteur et parfumeur
Un régulateur génétique qui améliore la santé des plantes et optimise leur « production » de parfum, identifié et documenté par cette équipe de biologistes et d’horticulteurs de la Nanjing Agricultural University, dans la revue spécialisée Horticulture Research, apporte ici un exemple de gène régulateur de la santé et de la résistance aux maladies. Avec des implications plus immédiates pour l’agriculture durable, et plus expérimentales, pour de nouveaux traitements antimicrobiens chez l’Homme.
La recherche identifie ainsi, dans la lavande, un gène qui joue un double rôle d’’amélioration des composés aromatiques mais également de résistance aux maladies. C’est en régulant de manière positive la biosynthèse de 2 composés, le linalol et le caryophyllène, au rôle clé dans la résistance aux agents pathogènes courants, que ce gène joue un rôle de protection.
Les plantes sont, comme les humains, confrontées à différentes pressions et agressions environnementales,
dont des facteurs de stress biotiques tels que les agents pathogènes, et des facteurs de stress abiotiques comme les températures extrêmes.
Parmi les facteurs de stress biotiques, donc relatifs à l’agression par des pathogènes vivants, chez les plantes, une bactérie, Pseudomonas syringae constitue une menace pour la santé, à l’instar d’autres bactéries pour la santé humaine.
Des anti-oxydants, les terpénoïdes, dont le linalol et le caryophyllène, jouent un rôle crucial dans les mécanismes de défense
des plantes contre ces facteurs de stress. Cependant, la régulation transcriptionnelle de ces composés protecteurs reste moins comprise. Décrypter les mécanismes de régulation qui sous-tendent la biosynthèse des terpénoïdes pourrait contribuer à identifier aussi de nouvelles cibles favorables à la santé humaine.
Les chercheurs de l'Académie chinoise des sciences identifient ici un facteur de transcription, LaMYC7, qui, dans la lavande, améliore considérablement la biosynthèse du linalol et du caryophyllène et renforce la résistance de la plante à la bactérie Pseudomonas syringae. Cette découverte inspire certainement des applications dans le développement de variétés de lavande plus résistantes mais lire aussi un modèle de régulation transcriptionnelle de la biosynthèse de ces composés bénéfiques que sont ici les terpénoïdes.
L'étude menée à l’aide de techniques de séquençage de l'ARN révèle que :
- le gène régulateur LaMYC7 est fortement exprimé en réponse à des stress tels que la lumière UV, les basses températures, le sel, la sécheresse, le jasmonate de méthyle (un COV utilisé dans de nombreuses voies de développement des plantes), et l'infection à Pseudomonas syringae ;
- la surexpression du gène LaMYC7 améliore la biosynthèse des terpénoïdes et augmente ainsi sa teneur en en linalol et en caryophyllène ;
- un des terpénoïde, le linalol démontre une forte activité antimicrobienne contre Pseudomonas syringae ;
- pris ensemble, ces résultats suggèrent que ce gène LaMYC7 est crucial pour la résistance aux agents pathogènes.
Cette identification d’un régulateur clé des mécanismes de défense, ici des plantes au niveau moléculaire, va contribuer au développement de pratiques agricoles durables mais suggère aussi des implications en santé humaine, avec l’identification possible de mécanismes similaires chez l'Homme, et de régulateurs humains de notre résistance aux maladies.
